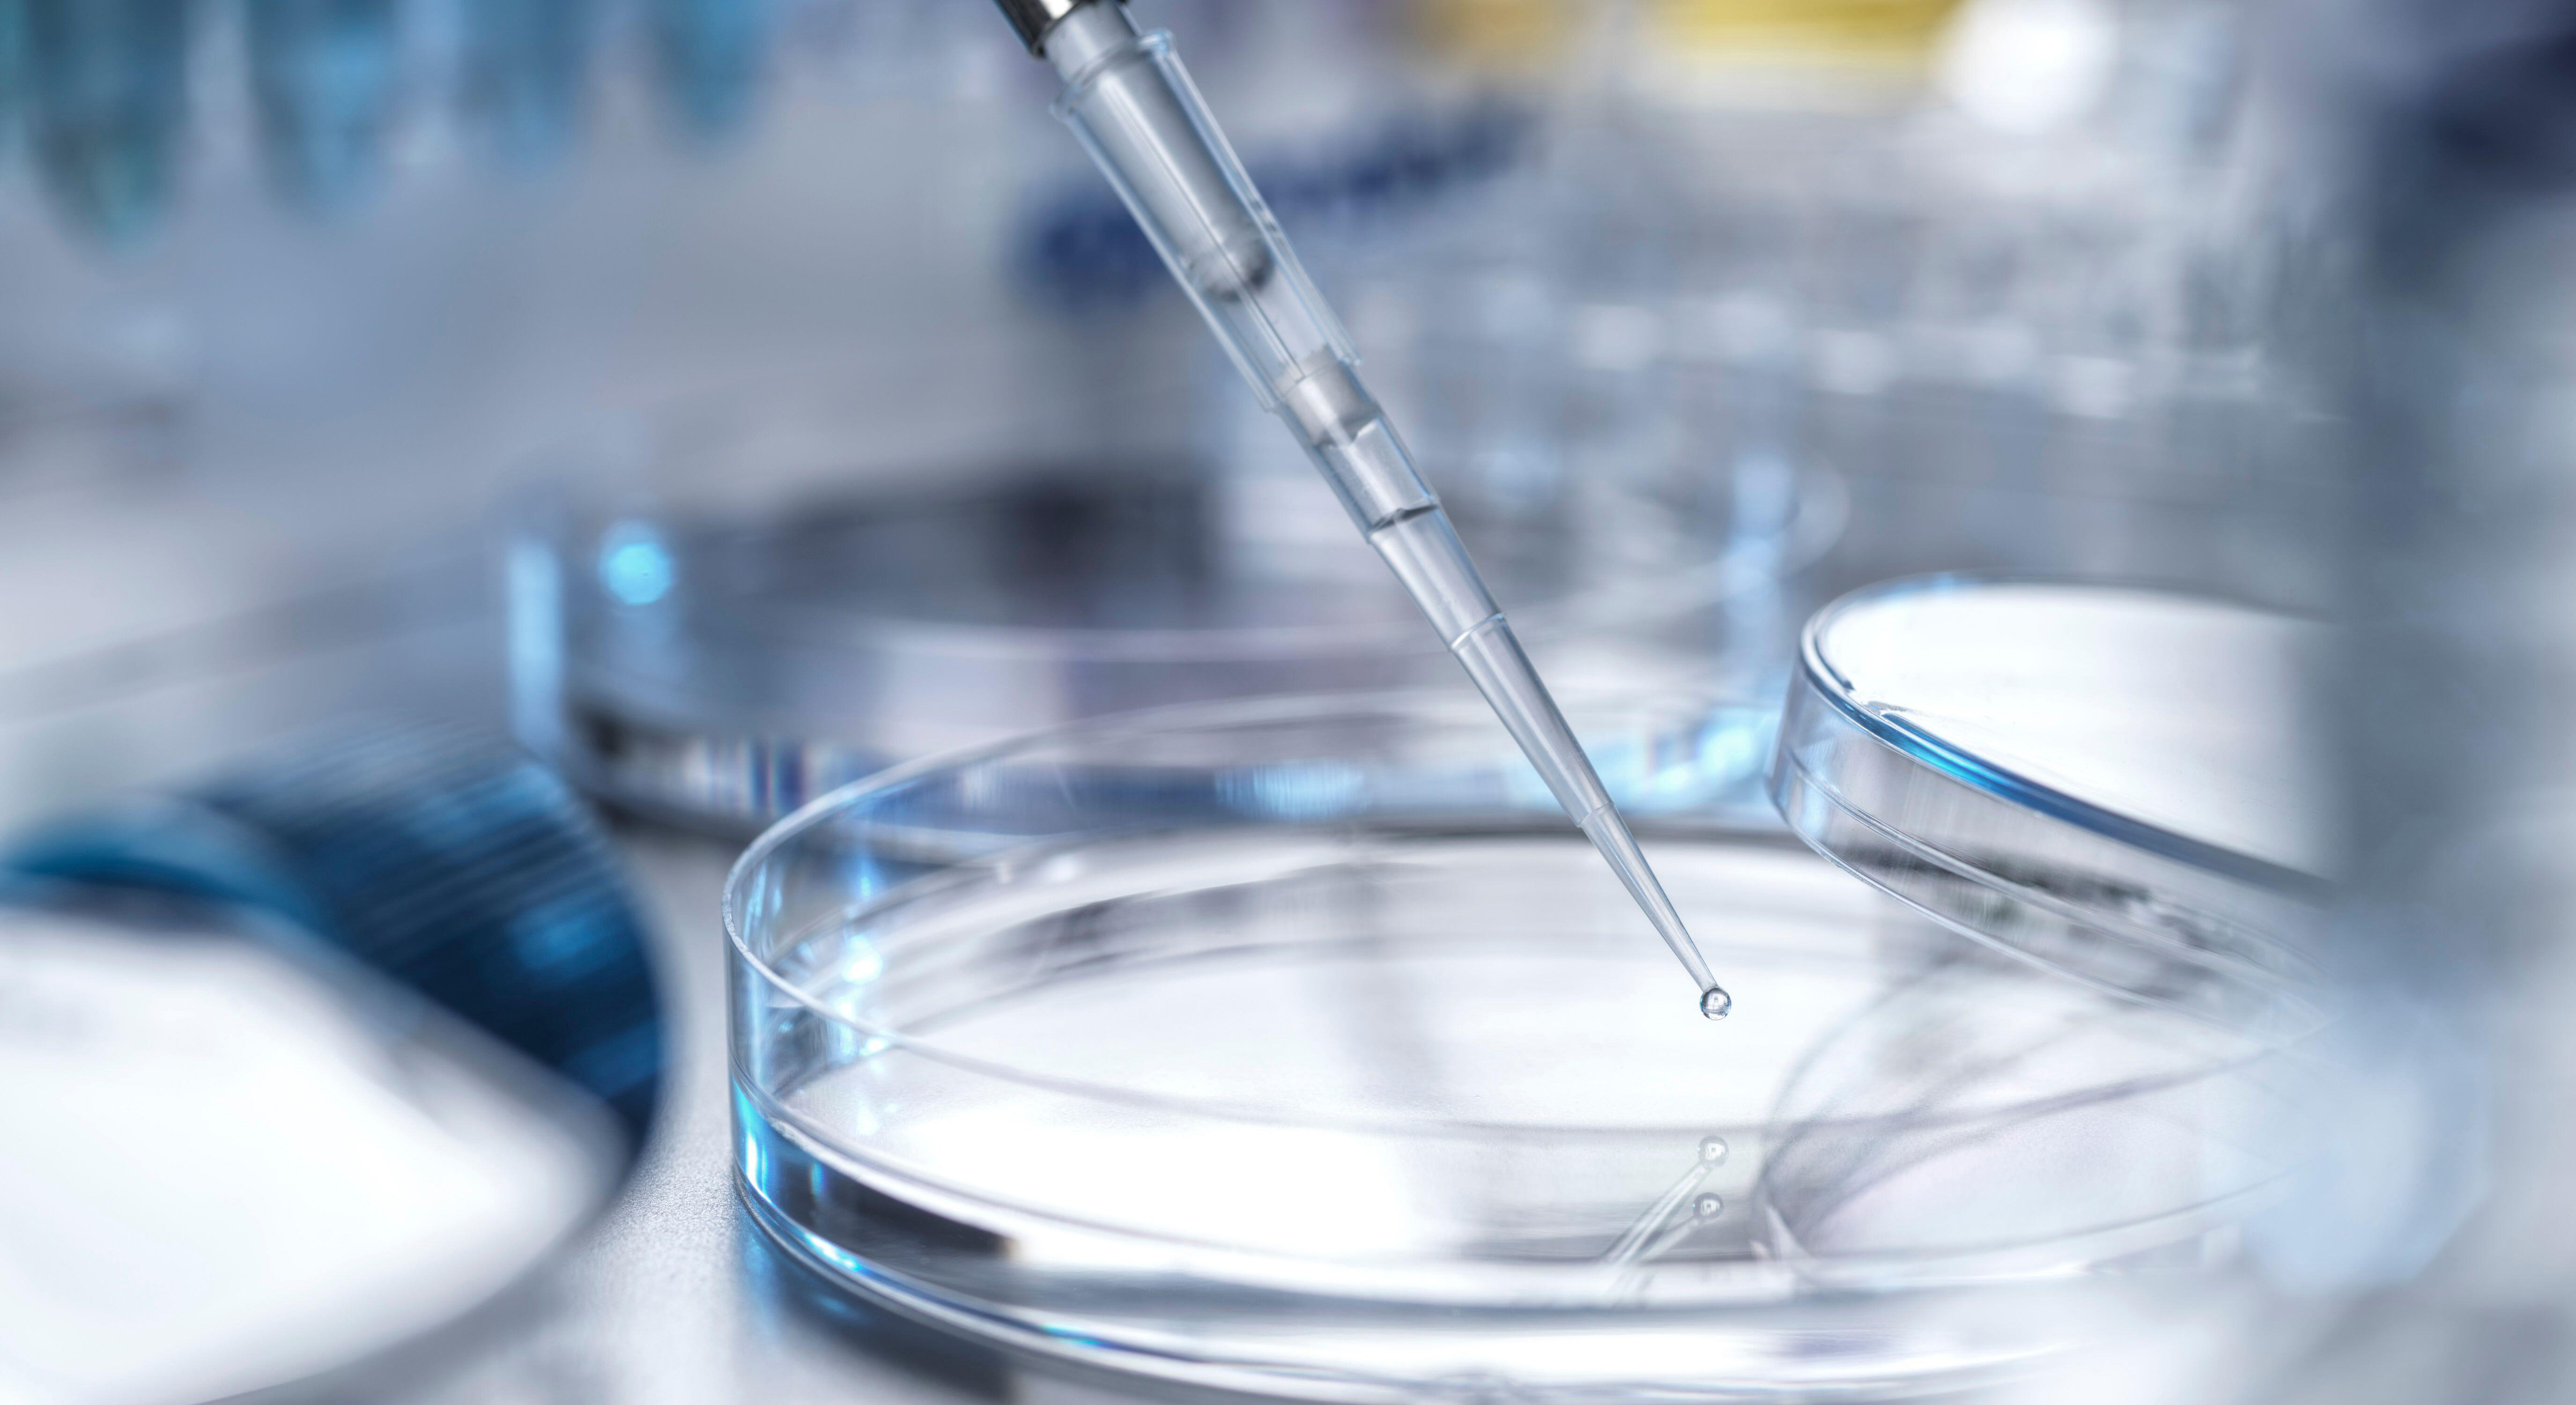

FOCUS // Made For Digital Conferences
Cut Through The Noise and Dive Into The Topics That Matter to You
Be Engaged and Inspired with Insights from Pioneers in Clinical Trials, BioProcessing, TIDES, Antibodies and Much More...
Break Down Geographical Barriers & Redefine Your Learning
Robust Content Driven Events With the Flexibility to Learn from Wherever You Are
TIDES Series
Therapeutic Area Partnerships Series
Medical Devices & Regulation Series
Be Seen. Be Heard. Be Trusted.
Put yourself at the forefront of the audience that matters to you and engage highly qualified life science prospects at targeted, 1-day & 2-day digital events.
A unique opportunity for your organisation, FOCUS provides you with the opportunity to:
- Be positioned as thought leaders amongst industry experts in the field
- Open yourself up to a targeted, niche network that truly engage with your product
- Place your product/technology in line with an agenda covering niche topics that will ensure the audience is made up of qualified leads, paying to attend an event on a very specific topic
- Position yourself alongside an industry led agenda: content and topics are based on industry trends and latest scientific discoveries and developments
- Engage thought-leaders and decision-makers without leaving the office or spending on travel, with the online digital format


A tour of the platform
Our best-in-class ConnectMe digital event platform makes it easier than ever for you to access today's leading science, technologies and networking opportunities within the global exosomes community.